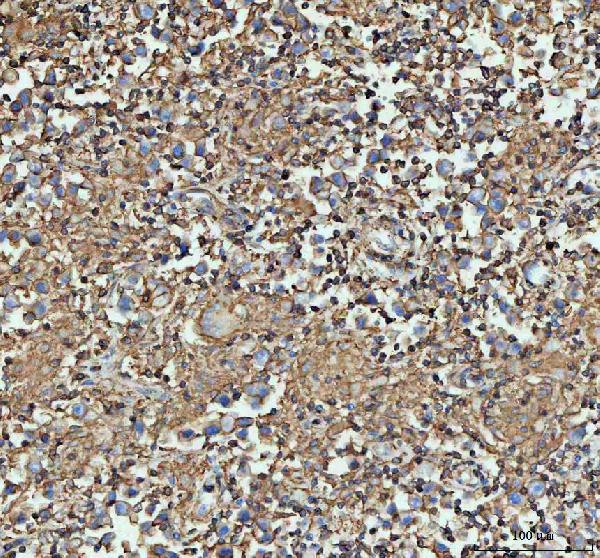
ACTA1 Antibody in Immunohistochemistry (Paraffin) (IHC (P))

Search
Invitrogen
ACTA1 Polyclonal Antibody
{{$productOrderCtrl.translations['antibody.pdp.commerceCard.promotion.promotions']}}
{{$productOrderCtrl.translations['antibody.pdp.commerceCard.promotion.viewpromo']}}
{{$productOrderCtrl.translations['antibody.pdp.commerceCard.promotion.promocode']}}: {{promo.promoCode}} {{promo.promoTitle}} {{promo.promoDescription}}. {{$productOrderCtrl.translations['antibody.pdp.commerceCard.promotion.learnmore']}}
图: 1 / 9
ACTA1 Antibody (PA5-78715) in IHC (P)









Please note: We are reviewing Western blot images included in the antibody testing data in our catalog, including those provided by third parties. Unless expressly labeled or annotated as “raw-unedited”, Western blot images included in the antibody testing data in our catalog may have been edited, optimized or otherwise adjusted for presentation.
产品信息
PA5-78715
种属反应
已发表种属
宿主/亚型
分类
类型
抗原
偶联物
形式
浓度
规格
纯化类型
保存液
内含物
保存条件
运输条件
RRID
产品详细信息
Reconstitute with 0.2 mL of distilled water to yield a concentration of 500 µg/mL.
Positive Control - WB: rat heart tissue, rat brain tissue, rat kidney tissue, mouse heart tissue, mouse brain tissue, mouse spleen tissue, mouse kidney tissue, human Hela whole cell, human HepG2 whole cell, human 293T whole cell, human A431 whole cell. IHC: human liver cancer tissue, human testicular germ cell tumor tissue, mouse heart tissue, rat heart tissue.
靶标信息
The product encoded by this gene belongs to the actin family of proteins, which are highly conserved proteins that play a role in cell motility, structure and integrity. Alpha, beta and gamma actin isoforms have been identified, with alpha actins being a major constituent of the contractile apparatus, while beta and gamma actins are involved in the regulation of cell motility. This actin is an alpha actin that is found in skeletal muscle. Mutations in this gene cause nemaline myopathy type 3, congenital myopathy with excess of thin myofilaments, congenital myopathy with cores, and congenital myopathy with fiber-type disproportion, diseases that lead to muscle fiber defects.
仅用于科研。不用于诊断过程。未经明确授权不得转售。
生物信息学
蛋白别名: actin alpha 1; Actin, alpha skeletal muscle; Alpha-actin-1
基因别名: AA959943; ACTA; Acta-2; ACTA1; Acts; Actsk-1
UniProt ID: (Mouse) P68134, (Rat) P68136
Entrez Gene ID: (Mouse) 11459, (Rat) 29437